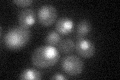
YDR097C
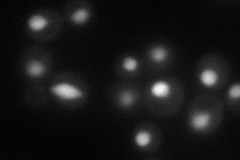
YDR097C
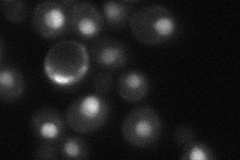
YDR097C
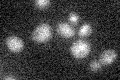
YDR097C

View description
Protein required for mismatch repair in mitosis and meiosis, forms a complex with Msh2p to repair both single-base & insertion-deletion mispairs; potentially phosphorylated by Cdc28p
Localization:
Intensity:
Fold change:
Significance:
-
C’ GFP library in SD
nucleus23.88 -
N' NOP1pr-GFP in SD
nucleus78.4189 -
N' TEF2pr-mCherry in SD

nucleus22.6567 -
N' NATIVEpr-GFP in SD
nucleus38.1608 -
N' TEF2pr-VC and Cyto-VN in SD

#N/A0 -
C’ GFP library in SD+DTT

nucleus160.66Yes -
C’ GFP library in SD+H2O2

nucleus25.951.08No -
C’ GFP library in Starvation Media
nucleus17.120.71Yes -
C’ GFP library on the background of Pup2-DaMP

nucleus -
C’ GFP library on the background of CCT mutant

nucleus20.54390.859882No
